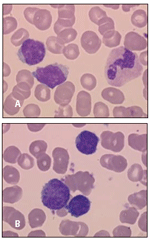

In this article, we review the current knowledge on the biological findings, clinical features, and therapeutic approaches for splenic marginal zone lymphoma.
Splenic marginal zone lymphoma (SMZL), along with extranodal marginal zone lymphoma of mucosa-associated lymphoid tissue (MALT lymphoma) and nodal marginal zone lymphoma (NMZL), share a common origin from the “marginal zone.” However, these three entities display different clinical characteristics, reflecting probable biological variations according to the organ and cellular origin. Within the past decade, new data have been reported regarding pathogenic mechanisms as well as therapeutic advances. Clinically, SMZL presents as an indolent and disseminated disease at diagnosis, with a specific clinical presentation that includes predominantly splenomegaly, and in half of patients, autoimmune manifestations. Establishing the diagnosis may be difficult, especially distinguishing SMZL from other low-grade lymphomas, such as small B-cell lymphomas; however, recent findings have contributed to a better characterization of the disease, and the criteria for diagnosis have been improved. Therapeutic approaches consist of splenectomy or immunochemotherapy, but there is no consensus regarding the best treatment, except when SMZL is associated with hepatitis C virus infection. In this article, we review the current knowledge on the biological findings, clinical features, and therapeutic approaches for SMZL.
Marginal zone lymphomas (MZLs) represent a group of lymphoid tumors that originate from memory B lymphocytes normally present in a distinct micro-anatomic compartment, the so-called marginal zone (MZ) of the secondary lymphoid follicles. The MZ is developed in those lymphoid organs where an abundant influx of antigens is known to occur. In particular, the MZ is especially developed in spleen- and mucosa-associated lymphoid tissues, whereas it is rarely identifiable in lymph nodes.[1] The last World Health Organization (WHO) classification[2] described three distinct subtypes of MZL, based on the site involved and characteristic molecular findings: (1) extranodal MZL of mucosa-associated lymphoid tissue (MALT lymphoma); (2) splenic MZL (SMZL); and (3) nodal MZL (NMZL).[2] Despite these advances in classification, patients with generalized disease at diagnosis are not easily categorized into precise diagnostic groupings. The relative rarity of these lymphomas, as well as the difficulties in distinguishing them from other low-grade lymphomas, poses crucial issues for the conduct of epidemiological surveys, and for the accurate description of clinical features and outcomes. The present review will focus on the most recent data on pathogenetic mechanisms, clinical features, and treatment of SMZL.
In adults, MZLs account for 5% to 17% of all non-Hodgkin lymphomas (NHLs), depending on the series. SMZL represents 20% of MZLs and accounts for less than 2% of NHLs.[3] The median age of occurrence is 65 years.[4,5] Clear evidence indicates that all MZL subtypes can be associated with chronic antigenic stimulation. Hepatitis C virus (HCV) infection has been highly correlated with lymphoplasmacytic immunocytoma,[6] SMZL,[7,8] and NMZL in some areas, such as Italy.[9] In the setting of SMZL, the co-occurrence of HCV infection is of major relevance, due to its possible therapeutic implications.[10] In SMZL associated with HCV infection, it has been demonstrated that the E2 glycoprotein of HCV could interact with CD81 in B cells and could be responsible for B-cell activation through the B-cell receptor, thereby leading to the increased proliferation of B cells.[11] In murine models, MZLs have been described following chronic stimulation by HCV, and have been associated with mutations of FAS, AP12/ML, and p53.[12] A special form of SMZL related to HCV has been correlated with the presence of cryoglobulin.[13] A decrease in lymphoproliferation following antiviral treatments reinforces the data, suggesting a contribution of chronic antigenic stimulation to the physiopathologic process of HCV-related MZL.[12,13]
Interestingly, SMZL, characterized by splenomegaly and circulating naive CD5-negative villous B lymphocytes, has been described in malaria-endemic areas (here denominated as tropical splenic lymphoma), strengthening the possible role of infectious agents in the pathogenesis of SMZL.[14]
The precise pathogenesis of SMZL is essentially unknown. The origin of SMZL is a marginal zone memory B cell, and in most cases it is posited as having a post-germinal origin, as demonstrated by the study of somatic mutations in Ig variable heavy chain (IGHV) region genes.[15-17] However, a limited degree of heterogeneity in the mutational profiles of SMZL cases has been described, and one-third of cases are nonmutated.[16,18] On the other hand, these lymphomas exhibit a low frequency of somatic mutations involving some oncogenes (BCL-6, PAX5, PIM1, RHO-H).[19] These findings suggest a particular differentiation pathway that may not involve transit through the germinal center.[16,19] Interestingly, a bias in the use of IGHV1-2*04 genes has been found, suggesting antigenic selection.[16,17]
FIGURE 1

Massive Splenomegaly in a Patient With a Splenic Marginal Zone Lymphoma.
The hallmark of the clinical presentation of SMZL is massive splenomegaly (Figure 1). However, most patients seek medical attention because of an abnormal blood cell count, especially anemia and/or thrombocytopenia. These abnormalities are more related to splenic sequestration than to bone marrow infiltration, and they are consistently associated with lymphocytosis.[11] Patients who present with an abnormal blood cell count are usually asymptomatic, but splenomegaly is detectable on clinical exam. In advanced cases of SMZL, patients present with massive splenomegaly associated with asthenia and left upper quadrant pain. B-symptoms are uncommon.
The serum lactate dehydrogenase (LDH) level is usually normal in SMZL, but the β2-microglobulin level is increased. A considerable proportion of patients (10% to 40% of cases) have a serum monoclonal paraprotein (M-component), mainly of the µ subtype (IgM).[11,20] Autoimmune clinical phenomena are described in 10% to 15% of patients, including autoimmune hemolytic anemia, immune thrombocytopenia, cold agglutinins, circulating anticoagulant (lupus anticoagulant and/or anticardiolipin antibodies), acquired von Willebrand disease, and angioedema due to acquired C1-esterase inhibitor deficiency.
HCV-associated SMZL is clinically indistinguishable from typical SMZL, except for the presence of HCV viral replication, the coexistence of liver disease, and the presence of cryoglobulinemia.[10]
FIGURE 2
Cytology of Splenic Marginal Zone Lymphoma in Blood
The diagnosis of SMZL is based on the study of peripheral blood lymphocytes, bone marrow biopsy specimens, or, when appropriate, surgical specimens from splenectomy. Most cases of SMZL do not require splenectomy for the diagnosis, which can be accurately determined on the basis of study of the bone marrow and peripheral blood (Figure 2). Revised criteria for SMZL diagnosis have been recently published, based on a collaborative effort.[21]
FIGURE 3

Histologic Aspect of Splenic Marginal Zone Lymphoma (SMZL)
Spleen histology (Figure 3) is still the gold standard for establishing the diagnosis, but it is often not sufficient. In addition, not all patients need splenectomy for therapy. According to the criteria proposed by the Splenic Lymphoma Group,[22] the minimum diagnostic criteria are either spleen histology plus immunophenotype with a Matutes score of 2 or less, or typical peripheral blood and bone marrow morphology plus immunophenotype. In addition, the recently discovered common finding of recurring molecular abnormality is sometimes of invaluable help in establishing the diagnosis.
The morphological diagnosis is for the most part easy, as it is based on identification of a marginal and biphasic pattern. However, small B-cell lymphomas involving the spleen preferentially involve the white pulp and may accentuate the normally present marginal zone structure in the spleen, thus mimicking SMZL and making it difficult to distinguish accurately between these entities and SMZL. In addition, lymphoma cells may show a variable degree of plasmacytic differentiation[23]; thus, distinguishing between lymphoplasmacytic lymphoma and SMZL, especially when the former is associated with an Ig spike, is not always easy. These difficulties in diagnosis reflect the lack of consensus criteria for diagnosis, underscored by the absence of specific immunologic or molecular markers; however, some recurrent molecular or cytogenetic abnormalities can help in the diagnosis. The 2001 WHO classification[24] defines SMZL as a B-cell neoplasm composed of small lymphocytes that surround and replace the white pulp follicles and merge with a peripheral zone of larger MZ-like cells, including scattered transformed blasts, thus giving rise to the characteristic biphasic pattern. The 2008 WHO classification[2] expanded this definition to include some cases that lacked a central core of smaller lymphocytes and that had a monophasic pattern. For those cases, other criteria-such as peripheral blood cytology, bone marrow histology, immunophenotype, and/or the presence of recurrent molecular or cytogenetic abnormalities are frequently required (see below). In cases with too few criteria for a definitive diagnosis, the choice of "unclassified splenic lymphoma" is preferred. This term applies to small B-cell clonal lymphoproliferations that involve the spleen but that do not fall under any of the other types of B-cell lymphoid neoplasm recognized in the WHO classification. The two best-defined of these relatively rare provisional entities are splenic diffuse red pulp lymphoma[25] and hairy cell leukemia-variant. The relationship of these entities to SMZL needs to be clarified in the future. Other splenic small B-cell lymphomas not fulfilling the criteria for either of these provisional entities or for other better-established B-cell lymphomas should be diagnosed as "splenic B-cell lymphoma/leukemia, unclassifiable" until more is known. Transformation to large B-cell lymphoma may also occur in SMZL, as in other indolent B-cell lymphomas.[21]
REFERENCE GUIDE
Therapeutic Agents
Mentioned in This Article
2-Chlorodeoxyadenosine
Bendamustine (Treanda)
Cladribine
Cyclophosphamide
Dexamethasone
Fludarabine
Mitoxantrone
Pegylated interferon-α
Prednisone
Ribavirin
Rituximab (Rituxan)
Vincristine
Brand names are listed in parentheses only if a drug is not available generically and is marketed as no more than two trademarked or registered products. More familiar alternative generic designations may also be included parenthetically.
The immunophenotypic analysis of the tumor cells shows CD19+, CD20+, CD5−, CD10−, CD23−, CD43±, FMC7±, CD103−, bcl-2+, and cyclin D1− cells. However, expression of CD5 is found in 15% to 25% of cases. Coexpression of IgM and IgD surface immunoglobulin (SIg) is characteristic of SMZL. The Matutes international score (based on CD5, FMC7, CD22 or CD79b, CD23, SIg expression) is generally below 3.[21]
Initial analyses of the mutational status of the IGHV genes have reported the presence of somatic hypermutation in most cases, which is in line with the origin of SMZL from a post-germinal MZ memory B cell.[17] However, more recent studies have found an absence of somatic mutations in one-third of studied cases, possibly reflecting a relative degree of molecular heterogeneity of SMZL.[15,17] In addition, SMZL B cells express a biased repertoire, with a preferential usage of certain IGHV genes, such as IGHV1-2*04 (31%), IGHV3-23 (8%), and IGHV4-34 (13%); also, approximatively 10% of cases express B-cell receptors (BCRs) with quasi-identical IGHV sequences, including the antigen binding site, strongly suggesting that antigen selection might contribute to the development of SMZL.[14] Antigen selection is particularly evident in HCV-associated SMZL, since a fraction of cases express a BCR that has rheumatoid factor activity, with heavy and light chain encoded by the IGHV1-69 and IGKV3-20 genes, respectively.
It has been reported that SMZLs with a VH1-2 rearrangement produce polyreactive antibodies that react against self antigens.[26] The presence of these antibodies argues for antigenic interactions through highly conserved residues located throughout the VH domain, raising the possibility that a superantigen is involved in lymphomagenesis and/or that lymphomas likely derive from polyreactive B cells.[25] In contrast, SMZLs exhibit a low frequency of somatic mutations involving non-Ig genes-such as BCL6 and/or PAX5, PIM1, or RHO-H-suggesting a particular differentiation pathway from the cell of origin without transit through the germinal center.[18]
Cytogenetic analyses in SMZL demonstrate that complex chromosomal aberrations are common (72% of cases have an abnormal karyotype and 53% of these cases have complex abnormalities). Deletion of chromosome 7q31 and complete or partial trisomy 3 are the most frequent cytogenetic abnormalities.[27-30] No tumor suppressor genes have been found in the region of deletion 7q31, and evidence supports the notion that the deletion of a cluster of miRNAs (MIR29A and MIR29B) located in this region could contribute to the deregulation of some of the key oncogenes in this disorder, such as TCL1.[31] Loss of sonic hedgehog gene (SHH) at 7q36.2 has been reported (four cases), and loss of protection of telomere 1 gene (POT1) has been suggested.[32] A particular miRNA profile has been described.[33]
Other cytogenetic alterations involving the chromosomes 8, 9p34, 12q23-24, 18q, and 17p have been described.[30] More rare translocations involving CDK6 and cyclinD3 with IgH have been identified in small subsets of cases.[34] Del13q14.3, which is the hallmark of chronic lymphocytic leukemia (CLL) when isolated, can be seen in less than 10% of cases. A translocation t(11;14)(q13;q32) combined with a rearrangement of BCL-1 and/or the expression of cyclin D1 was described in 15% of cases diagnosed as splenic B-cell lymphoma with villous lymphocytes (SLVL), but these cases seem to harbor other morphological, phenotypic, and cytogenetic features that suggest a diagnosis of mantle cell lymphoma.[35-37]
Overall, cytogenetics should not be considered in isolation for diagnostic purposes, although when these findings are considered along with other disease features they may reinforce or support a suspected diagnosis of SMZL.
Recent genome-wide DNA profiling confirmed the cytogenetic data described above in a large series of 218 MZLs. Common abnormalities found in all subtypes (extranodal, splenic, and nodal) included gains of 3q and 18q (which appeared to affect BCR signaling and Wnt signaling, cell cycle, and apoptosis).[38] More specific abnormalities that were described in SMZL included del(7q31) and del(8p).
TABLE 1

Diagnosis and Staging Procedures for Splenic Marginal Zone Lymphoma
None of the above-mentioned cytogenetic abnormalities, with the exception of the 7q32 deletion, is considered typical of SMZL, but they may be helpful for establishing the diagnosis, particularly when the differential diagnosis includes CLL, hairy cell leukemia, mantle cell lymphoma, follicular lymphoma, or lymphoplasmacytic lymphoma (Table 1). Unlike with MALT lymphoma, translocations involving the MALT 1 gene are not found in SMZL. In terms of prognostic impact, only the association with del(17p) and del(8p) had a significant negative impact on the outcome of SMZL.
Although it cannot yet be applied to routine diagnosis, gene expression analysis clearly shows that SMZLs have a specific transcriptional profile compared with other lymphomas-especially small B-cell lymphomas, such as follicular lymphomas, lymphocytic lymphomas, and mantle cell lymphomas.[35,36] This specific molecular signature includes genes involved in the signaling cascade of the AKT1 pathway,[37] as well as the BCR signaling pathway, and tumor necrosis factor (TNF) and nuclear factor–kappa B (NF-κB) targets.[35] The importance of the latter pathway in the pathogenesis of SMZL has been strongly underscored by the detection of mutually exclusive somatic mutations of NF-κB genes, such as TNFAIP3, IKBKB, MAP3K14, TRAF3, and BIRC3, in more than one-third of cases.[39]
TABLE 2

Clinical and Biological Adverse Prognostic Factors in Splenic Marginal Zone Lymphoma
The median overall survival in SMZL ranges between 5 and 10 years, but in cases of aggressive disease, seen in approximately one-third of patients, median survival is less than 4 years.[40] Clinical and biological prognostic factors have been identified by several investigators (Table 2). The Italian Intergroup of Lymphomas (IIL) has developed a prognostic model based on the tracking of three factors (hemoglobin level less than 12 g/dL, lactate dehydrogenase level greater than normal, and albumin level less than 3.5 g/dL) in 309 patients, leading to a prognostic index.[41] This index allows one to separate patients into three groups, each with a different 5-year survival rate: 88% in the low-risk group (no risk factors), 73% in the intermediate-risk group (one risk factor), and 50% in the high-risk group (more than one risk factor). However, this index has not yet been demonstrated to have any therapeutic implications. In this analysis, the International Prognostic Index (IPI) was found to predict survival, although the multivariate analysis selected the three indicated parameters. Other biologic prognostic factors have been described based on gene expression analysis; these include expression of CD38, unmutated IGHV gene status, and expression of NF-κB–activated genes.[42]
Histologic transformation to large-cell lymphoma remains uncommon, occurring in 10% to 20% of patients. Diffuse large B-cell lymphoma, when it involves the spleen, is usually characterized by one or several large nodules, very rarely involving the bone marrow. Transformation occurs within a median interval ranging from 12 to 85 months.[43] The transformation presents clinically as the appearance of general symptoms, an increase in LDH level, and disseminated lymphoma involvement. After histologic progression, the median survival time is shortened to 26 months.[5]
Treatment is required only in symptomatic patients with painful splenomegaly, with or without associated cytopenia due to hypersplenism. Asymptomatic patients, who constitute a large percentage of patients, can be appropriately managed with watchful waiting for several years. Withholding treatment does not influence the course of disease, and these patients often have stable disease for at least 10 years.[7] The only exception to this management approach is in the setting of SMZL associated with active HCV infection. Antiviral therapy with pegylated interferon-α and ribavirin will lead to clearance of HCV RNA in 75% of patients and to concomitant clinical remission of the lymphoma.[44]
TABLE 3

Response to Treatment in Splenic Marginal Zone Lymphoma
When patients become symptomatic because of anemia (hemoglobin level < 10 g/dL), abdominal pain, thrombocytopenia (platelet count < 80 × 109/L),[41] several treatment options may be proposed to them. Splenectomy will rapidly improve performance status and correct anemia, thrombocytopenia, and neutropenia within 6 months of the procedure.[19] This improvement is maintained for years, with a median period of freedom from treatment of 8 years, even if bone marrow and blood lymphocytosis persist, suggesting a partial response. Adjuvant chemotherapy following splenectomy provides an increased remission rate without modifying relapse-free and overall survival.[5] For patients who are unfit for splenectomy or unwilling to undergo surgery, systemic therapy may be effective (Table 3). Rituximab (Rituxan) alone is reported to provide an excellent response rate, with a shorter progression-free survival than that observed when rituximab is combined with cladribine or fludarabine or polychemotherapy.[8,19,45-50] Recently, bendamustine (Treanda) has emerged as a highly effective drug for NHL, including MZLs.[51] A European trial evaluating the combination of rituximab and bendamustine in patients with MZLs is scheduled to begin in the near future (EudraCT number 2011-000880-28). For clinical trials to be evaluated, however, it is necessary to develop consistent staging and response criteria for the disease. The recent workshop of the International MZL group has redefined these parameters (Table 4).[21]
TABLE 4

Response Criteria in Splenic Marginal Zone Lymphoma
SMZL is considered to be a distinct entity among NHLs, with definite clinical and morphological characteristics. Although this entity is characterized by very different clinical presentations, strong similarities in the epidemiology and the biology of the tumor cells support a common origin in the memory B cells of the marginal zone. In the past 5 years, a large collaborative effort by biologists, pathologists, and clinicians has resulted in agreement on more stringent criteria for the diagnosis of the disease and for the evaluation of clinical response. These efforts should support the design of further prospective clinical trials to define the optimal therapeutic approach to this disease.
Financial Disclosure:The authors have no significant financial interest or other relationship with the manufacturers of any products or providers of any service mentioned in this article.
1. Weill JC, Weller S, Reynaud CA. Human marginal zone B cells. Annu Rev Immunol. 2009;27:267-85.
2. Swerdlow S, Campo E, Harris N, et al. WHO classification of tumours of haematopoietic and lymphoid tissue. Lyon, France: International Agency for Research on Cance Press; 2008.
3. Berger F, Felman P, Thieblemont C, et al. Non-MALT marginal zone B-cell lymphomas: a description of clinical presentation and outcome in 124 patients. Blood. 2000;95:1950-6.
4. Oscier D, Owen R, Johnson S. Splenic marginal zone lymphoma. Blood Rev. 2005;19:39-51.
5. Thieblemont C, Felman P, Berger F, et al. Treatment of splenic marginal zone B-cell lymphoma: an analysis of 81 patients. Clin Lymphoma. 2002;3:41-7.
6. Silvestri F, Barillari G, Fanin R, et al. Impact of hepatitis C virus infection on clinical features, quality of life and survival of patients with lymphoplasmacytoid lymphoma/immunocytoma. Ann Oncol. 1998;9:499-504.
7. Arcaini L, Burcheri S, Rossi A, et al. Nongastric marginal-zone B-cell MALT lymphoma: prognostic value of disease dissemination. Oncologist. 2006;11:285-91.
8. Arcaini L, Paulli M, Boveri E, et al. Splenic and nodal marginal zone lymphomas are indolent disorders at high hepatitis C virus seroprevalence with distinct presenting features but similar morphologic and phenotypic profiles. Cancer. 2004;100:107-15.
9. Arcaini L, Burcheri S, Rossi A, et al. Prevalence of HCV infection in nongastric marginal zone B-cell lymphoma of MALT. Ann Oncol. 2007;18:346-50.
10. Hermine O, Lefrere F, Bronowicki J, et al. Regression of splenic lymphoma with villous lymphocytes after treatment of hepatitis C virus infection. N Engl J Med. 2002;11:89-94.
11. Thieblemont C, Felman P, Callet-Bauchu E, et al. Splenic marginal-zone lymphoma: a distinct clinical and pathological entity. Lancet Oncol. 2003;4:95-103.
12. Morse HC, Kearney JF, Isaacson PG, et al. Cells of the marginal zone-origins, function and neoplasia. Leuk Res. 2001;25:169-78.
13. Saadoun D, Boyer O, Trebeden-Negre H, et al. Predominance of type 1 (Th1) cytokine production in the liver of patients with HCV-associated mixed cryoglobulinemia vasculitis. J Hepatol. 2004;41:1031-7.
14. Bates I, Bedu-Addo G, Jarrett RF, et al. B-lymphotropic viruses in a novel tropical splenic lymphoma. Br J Haematol. 2001;112:161-6.
15. Boveri E, Arcaini L, Merli M, et al. Bone marrow histology in marginal zone B-cell lymphomas: correlation with clinical parameters and flow cytometry in 120 patients. Ann Oncol. 2009;20:129-36.
16. Traverse-Glehen A, Davi F, Ben Simon E, et al. Analysis of VH genes in marginal zone lymphoma reveals marked heterogeneity between splenic and nodal tumors and suggests the existence of clonal selection. Haematologica. 2005;90:470-8.
17. Zibellini S, Capello D, Forconi F, et al. Stereotyped patterns of B-cell receptor in splenic marginal zone lymphoma. Haematologica. 2010;95:1792-6.
18. Algara P, Mateo MS, Sanchez-Beato M, et al. Analysis of the IgV(H) somatic mutations in splenic marginal zone lymphoma defines a group of unmutated cases with frequent 7q deletion and adverse clinical course. Blood. 2002;99:1299-304.
19. Traverse-Glehen A, Verney A, Baseggio L, et al. Analysis of BCL-6, CD95, PIM1, RHO/TTF and PAX5 mutations in splenic and nodal marginal zone B-cell lymphomas suggests a particular B-cell origin. Leukemia. 2007;21:1821-4.
20. Parry-Jones N, Matutes E, Gruszka-Westwood AM, et al. Prognostic features of splenic lymphoma with villous lymphocytes: a report on 129 patients. Br J Haematol. 2003;120:759-64.
21. Dungarwalla M, Appiah-Cubi S, Kulkarni S, et al. High-grade transformation in splenic marginal zone lymphoma with circulating villous lymphocytes: the site of transformation influences response to therapy and prognosis. Br J Haematol. 2008;143:71-4.
22. Matutes E, Oscier D, Montalban C, et al. Splenic marginal zone lymphoma proposals for a revision of diagnostic, staging and therapeutic criteria. Leukemia. 2008;22:487-95.
23. Duong Van Huyen JP, Molina T, Delmer A, et al. Splenic marginal zone lymphoma with or without plasmacytic differentiation. Am J Surg Pathol. 2000;24:1581-92.
24. Jaffe ES, Harris NL, Stein H, Vardiman J. World Health Organization Classification of Tumours: Pathology and genetics of tumours of haematopoietic and lymphoid tissues. Lyon, France: IARC Press; 2001.
25. Traverse-Glehen A, Baseggio L, Callet-Bauchu E, et al. Hairy cell leukaemia-variant and splenic red pulp lymphoma: a single entity? Br J Haematol. 2010;150:113-6.
26. Warsame AA, Aasheim HC, Nustad K, et al. Splenic marginal zone lymphoma with VH1-02 gene rearrangement expresses poly- and self-reactive antibodies with similar reactivity. Blood. 2011;118:3331-9.
27. Callet-Bauchu E, Baseggio L, Felman P, et al. Cytogenetic analysis delineates a spectrum of chromosomal changes that can distinguish non-MALT marginal zone B-cell lymphomas among mature B-cell entities: a description of 103 cases. Leukemia. 2005;19:1818-23.
28. Dierlamm J, Rosenberg C, Stul M, et al. Characteristic pattern of chromosomal gains and losses in marginal zone B cell lymphoma detected by comparative genomic hybridization. Leukemia. 1997;11:747-58.
29. Sole F, Salido M, Espinet B, et al. Splenic marginal zone B-cell lymphomas: two cytogenetic subtypes, one with gain of 3q and the other with loss of 7q. Haematologica. 2001;86:71-7.
30. Salido M, Baro C, Oscier D, et al. Cytogenetic aberrations and their prognostic value in a series of 330 splenic marginal zone B-cell lymphomas: a multicenter study of the Splenic B-Cell Lymphoma Group. Blood. 2010;116:1479-88.
31. Aggarwal M, Villuendas R, Gomez G, et al. TCL1A expression delineates biological and clinical variability in B-cell lymphoma. Mod Pathol. 2009;22:206-15.
32. Vega F, Cho-Vega JH, Lennon PA, et al. Splenic marginal zone lymphomas are characterized by loss of interstitial regions of chromosome 7q, 7q31.32 and 7q36.2 that include the protection of telomere 1 (POT1) and sonic hedgehog (SHH) genes. Br J Haematol. 2008;216-26.
33. Bouteloup M, Verney A, Rachinel N, et al. MicroRNA expression profile in splenic marginal zone lymphoma. Br J Haematol. 2012;156:279-81.
34. Corcoran M, Mould S, Orchard J, et al. Dysregulation of cyclin dependent kinase 6 expression in splenic marginal zone lymphoma through chromosome 7q translocations. Oncogene. 1999;18:6271-7.
35. Cuneo A, Bardi A, Wlodarska I, et al. A novel recurrent translocation t(11;14)(p11;q32) in splenic marginal zone B cell lymphoma. Leukemia. 2001;
15:1262-7.
36. Jadayel D, Matutes E, Dyer M, et al. Splenic lymphoma with villous lymphocytes: analysis of bcl-1 rearrangements and expression of the cyclin D1 gene. Blood. 1994;83:3664-71.
37. Oscier DG, Matutes E, Gardiner A, et al. Cytogenetic studies in splenic lymphoma with villous lymphocytes. Br J Haematol. 1993;85:487-91.
38. Rinaldi A, Mian M, Chigrinova E, et al. Genome-wide DNA profiling of marginal zone lymphomas identifies subtype-specific lesions with an impact on the clinical outcome. Blood. 2011;117:1595-604.
39. Rossi D, Deaglio S, Dominguez-Sola D, et al. Alteration of BIRC3 and multiple other NF-κB pathway genes in splenic marginal zone lymphoma. Blood. 2011;118:4930-4.
40. Bertoni F, Zucca E. State-of-the-art therapeutics: marginal-zone lymphoma. J Clin Oncol. 2005;23:6415-20.
41. Arcaini L, Lazzarino M, Colombo N, et al. Splenic marginal zone lymphoma: a prognostic model for clinical use. Blood. 2006;107:4643-9.
42. Ruiz-Ballesteros E, Mollejo M, Rodriguez A, et al. Splenic marginal zone lymphoma: proposal of new diagnostic and prognostic markers identified after tissue and cDNA microarray analysis. Blood. 2005;106:1831-8.
43. Camacho FI, Mollejo M, Mateo MS, et al. Progression to large B-cell lymphoma in splenic marginal zone lymphoma - a description of a series of 12 cases. Am J Surg Pathol. 2001;25:1268-76.
44. Vallisa D, Bernuzzi P, Arcaini L, et al. Role of anti-hepatitis C virus (HCV) treatment in HCV-related, low-grade, B-cell, non-Hodgkin's lymphoma: a multicenter Italian experience. J Clin Oncol. 2005;23:468-73.
45. Chacon J, Mollejo M, Munoz E, et al. Splenic marginal zone lymphoma: clinical characteristics and prognostic factors in a series of 60 patients. Blood. 2002;100:1648-54.
46. Kalpadakis C, Pangalis GA, Dimopoulou MN, et al. Rituximab monotherapy is highly effective in splenic marginal zone lymphoma. Hematol Oncol. 2007;25:127-31.
47. Lefrere F, Hermine O, Belanger C, et al. Fludarabine: an effective treatment in patients with splenic lymphoma with villous lymphocytes. Leukemia. 2000;14:573-5.
48. Tsimberidou AM, Catovsky D, Schlette E, et al. Outcomes in patients with splenic marginal zone lymphoma and marginal zone lymphoma treated with rituximab with or without chemotherapy or chemotherapy alone. Cancer. 2006;107:125-35.
49. Bennett M, Sharma K, Yegena S, et al. Rituximab monotherapy for splenic marginal zone lymphoma. Haematologica. 2005;90:856-8.
50. Cervetti G, Galimberti S, Cecconi N, et al. Role of low-dose 2-CdA in refractory or resistant lymphoplasmacytic lymphoma. J Chemother. 2004;16:388-91.
51. Cheson BD, Friedberg JW, Kahl BS, et al. Bendamustine produces durable responses with an acceptable safety profile in patients with rituximab-refractory indolent non-Hodgkin lymphoma. Clin Lymphoma Myeloma Leuk. 2010;10:452-7.
Navigating AE Management for Cellular Therapy Across Hematologic Cancers
A panel of clinical pharmacists discussed strategies for mitigating toxicities across different multiple myeloma, lymphoma, and leukemia populations.
Late Hepatic Recurrence From Granulosa Cell Tumor: A Case Report
Granulosa cell tumors exhibit late recurrence and rare hepatic metastasis, emphasizing the need for lifelong surveillance in affected patients.